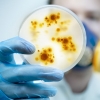
버스서 갑자기 사망한 中 남성, ‘한타바이러스’ 양성 확인

-

‘대한매일신보 창간’ 베델 선생 서거 111주년
2020-05-01 서울신문 -

‘대한매일신보 창간’ 베델 선생 서거 111주년
2020-05-01 서울신문 -

“애견 해수욕장 절대 안돼요”…영덕 대진해수욕장 인근 주민 반발 무산
2020-04-28 서울Pn -

삼성 반도체 공장 근처에 수달이 돌아온 까닭
2020-04-23 서울신문 -

삼성 반도체 공장 근처에 수달이 돌아온 까닭
2020-04-23 서울신문 -

‘대한매일신보 창간 주도’ 양기탁 선생 서거 82주년
2020-04-20 서울신문 -

‘대한매일신보 창간 주도’ 양기탁 선생 서거 82주년
2020-04-20 서울신문 -
![[은기자의 왜떴을까] 당신이 ‘부부의 세계’에 빠진 몇가지 이유](https://img.seoul.co.kr/img/upload/2020/04/17/SSI_20200417165940_S.jpg)
[은기자의 왜떴을까] 당신이 ‘부부의 세계’에 빠진 몇가지 이유
2020-04-17 서울En -

코로나19 숙주인 박쥐에서 ‘신종 바이러스’ 또 나왔다 (연구)
2020-04-14 나우뉴스 -

백원우 “쓰레기 같은 정당” 비판에 통합당 “역대급 막말”
2020-04-12 서울신문 -

설사, 피부 트러블 유발하는 헬스 보충제? 이제 그만
2020-04-08 서울신문 -

“고양이 코로나19 감염, 전파 가능”… 하지만 걱정은 NO
2020-04-03 서울신문 -

中연구팀, 동물 대상 코로나19 ‘의도적 감염’ 실험 결과 공개
2020-04-02 나우뉴스 -
버스서 갑자기 사망한 中 남성, ‘한타바이러스’ 양성 확인
2020-03-25 나우뉴스 -

페루 ‘기니피그 고기’ 수출 증가…‘꽃청춘’도 놀랐던 그 요리
2020-03-17 나우뉴스 -
![[근대광고 엿보기] ‘말하는 기계’와 한국 최초의 음반](https://img.seoul.co.kr/img/upload/2020/03/15/SSI_20200315190726_S.jpg)
[근대광고 엿보기] ‘말하는 기계’와 한국 최초의 음반
2020-03-16 서울신문 -
놀이시설 청소·소독·검사… 어린이가 안전한 동작
2020-03-12 서울Pn -

배 속이 온통 플라스틱 쓰레기…끙끙 앓던 새끼거북 바다 품으로
2020-03-11 나우뉴스 -
![[황규관의 고동소리] 손을 씻는 시간](https://img.seoul.co.kr/img/upload/2018/08/08/SSI_20180808173530_S.jpg)
[황규관의 고동소리] 손을 씻는 시간
2020-03-05 서울신문 -
![[핵잼 사이언스] 화성서 작물 재배, 대변 대신 소변으로 가능?!](https://imgnn.seoul.co.kr/img/upload/2020/02/28/SSI_20200228095207_S.jpg)
[핵잼 사이언스] 화성서 작물 재배, 대변 대신 소변으로 가능?!
2020-02-28 나우뉴스 -

버려진 비닐로 집 짓는 도심 다람쥐…동물 위협하는 플라스틱 쓰레기
2020-02-26 나우뉴스 -
![[곽병찬 칼럼] 표현의 자유, 지식인의 공깃돌이 아니다](https://img.seoul.co.kr/img/upload/2018/06/13/SSI_20180613224515_S.jpg)
[곽병찬 칼럼] 표현의 자유, 지식인의 공깃돌이 아니다
2020-02-20 서울신문 -

“‘코로나19’ 실험실 유출 주장은 가짜뉴스” 우한 연구소 주장
2020-02-17 서울신문 -

코로나19 환자 분변에서 바이러스 검출…새로운 전파 경로 가능성
2020-02-13 서울신문 -

10곳 중 6곳 질병 의심… 동물원 갔다가 병 얻을라
2020-01-31 서울신문 -

13만 마리 까마귀의 군무…겨울 철새 천국 울산, 날다
2020-01-30 서울Pn -
![[안녕? 자연] 구조된 바다거북 배설물서 인간이 버린 쓰레기 ‘와르르’](https://imgnn.seoul.co.kr/img/upload/2020/01/29/SSI_20200129142320_S.jpg)
[안녕? 자연] 구조된 바다거북 배설물서 인간이 버린 쓰레기 ‘와르르’
2020-01-29 나우뉴스 -
따뜻한 겨울 탓에 시름 깊어지는 농가들
2020-01-20 서울신문 -
![[사이언스 브런치] 고양이한테 덤비는 생쥐, 뇌 속 기생충 때문](https://img.seoul.co.kr/img/upload/2020/01/17/SSI_20200117160444_S.jpg)
[사이언스 브런치] 고양이한테 덤비는 생쥐, 뇌 속 기생충 때문
2020-01-17 서울신문 -
![[그들의 시선] 재가요양보호사, 만능 일꾼들의 애환](https://img.seoul.co.kr/img/upload/2020/01/17/SSI_20200117145214_S.jpg)
[그들의 시선] 재가요양보호사, 만능 일꾼들의 애환
2020-01-17 서울신문


